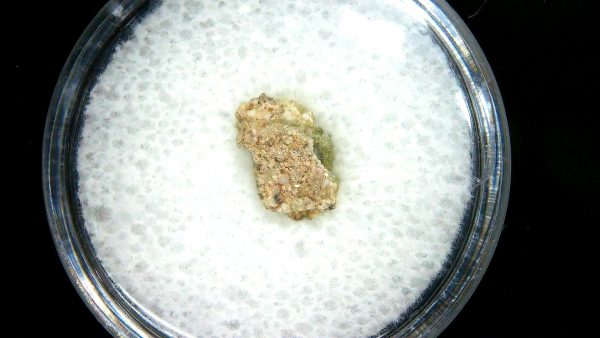
New Mexico Trinity Nuclear Bomb Test - Trinitite 78a | Fossils for Sale Genuine Trinity Nuclear Bomb Test in Frame for Sale from New Mexico #78a

Description
Trinitite Atomic Bomb
- Specimen will come in the 6.25″ x 8.25″ Riker Mount as Shown.
- The Trinitite Atomic Bomb Glass Piece is housed in the 1.25″ Gem Jar inside of the Riker Mount
- MORE Historical Artifacts for Sale
Trinitite is also called Alamogordo Glass. In fact, it is named after the Trinity Test Site located in Alamagaro New Mexico. As a result of the atomic blast the surrounding earth was liquified and turned to radioactive glass. All in all this is a very cool piece of history. It is usually a light green, although red trinitite was also found in one section of the blast site. As a result It is mildly radioactive but safe to handle.